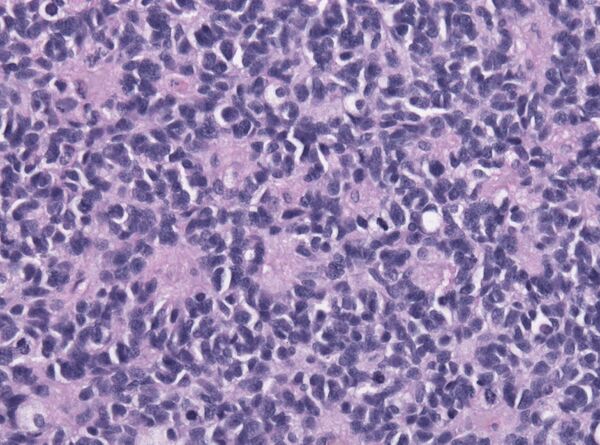

Медуллобластома
Медуллобласто́ма (примитивная нейроэктодермальная опухоль задней черепной ямки)[1] — злокачественная опухоль, которая развивается из эмбриональных клеток. Первичный узел новообразования располагается в задней черепной ямке в области средней линии мозжечка[2]. Преимущественно медуллобластомы встречаются у детей[3] и составляют у них около 20 % всех первичных опухолей центральной нервной системы.
Медуллобластомы — одни из немногих опухолей центральной нервной системы, которые метастазируют. Особенностью метастазирования данных новообразований является распространение опухолевых клеток по путям оттока спинномозговой жидкости в мягкую оболочку головного и спинного мозга и эпендиму желудочков мозга[4].
Клинические симптомы заболевания включают проявления гидроцефалии и повышения внутричерепного давления, а также непосредственного поражения срединных отделов мозжечка[1].
Лечение данной патологии должно быть комплексным. Хирургическое удаление дополняется лучевой и химиотерапией[5][6].
Пятилетняя выживаемость колеблется от 35 % (в группе высокого риска) до 75 % (в группе низкого риска)[5][6]. Наихудший прогноз заболевания — у больных с рецидивом опухоли после операции[7].
Общие сведения
Терминология
Термин «медуллобластома мозжечка» впервые был использован нейрохирургами Персивалем Бейли и Харви Кушингом в 1925 году. Под ним они понимали высокозлокачественную мелкоклеточную опухоль в области средней линии мозжечка[8]. Предложенное определение оставалось неизменным вплоть до 1983 года, когда учёными Рорке, Беккером и Хинтоном было высказано предположение о том, что все злокачественные мелкоклеточные опухоли центральной нервной системы (включая медуллобластому) являются примитивными нейроэктодермальными опухолями (англ. primitive neuroectodermal tumors — PNET). Согласно их работам медуллобластома отличается от PNET лишь своим месторасположением[9][10]. До этого под термином PNET подразумевались лишь супратенториальные (располагающиеся над намётом мозжечка) злокачественные мелкоклеточные опухоли. Считается, что данные опухоли происходят из эмбриональных клеток[2]. На 2011 год остаётся нерешённым вопрос о том, является ли медуллобластома примитивной нейроэктодермальной опухолью или отдельным видом злокачественного образования[1]. Классификация опухолей мозга Всемирной организации здравоохранения от 1993 года определяет медуллобластому как особую эмбриональную опухоль. PNET, согласно этой же классификации, представляет собой новообразование, гистологически неотличимое от медуллобластомы, которое находится вне мозжечка[11]. В целом термины «PNET задней черепной ямки» и «медуллобластома» считают синонимами[1].
Эпидемиология
Медуллобластомы составляют около 20 % всех первичных опухолей центральной нервной системы у детей. В США ежегодно на 1 миллион белого населения выявляют 2 новых случая медуллобластом, на 1 миллион чернокожего — 1 случай[12]. Преимущественно данный тип новообразований встречается у детей. У взрослых они чрезвычайно редки — ежегодно 5—6 новых случаев на 10 миллионов[13][14][15]. В структуре заболеваемости определяются 2 пика — от 3-х до 4-х и от 8-и до 9-и лет[3]. В Дании в 1960—1984 годах соотношение мальчиков и девочек среди больных медуллобластомами составило 2 к 1[16].
Патологическая анатомия
Макроскопически медуллобластомы представляют собой мягкий узел серовато-розового цвета, который чётко отграничен от окружающей ткани. Микроскопически опухоль состоит из густо расположенных недифференцированных клеток, которые образуют своеобразные структуры в виде правильных или беспорядочных рядов, которые сравнивают с «грядами» и «колоннами»[4].
Для гистологического строения медуллобластом характерны структуры в виде «розеток», образованных кольцевидно расположенными опухолевыми клетками, отростки которых сходятся в центре розетки. Опухолевые клетки обладают повышенной митотической активностью. Наряду с гиперхромными округлыми ядрами в клетках медуллобластом также встречаются овальные и вытянуто-овальные, удлинённые, а также более крупные светлые ядра с чётким ядрышком[4].
Строма опухоли содержит небольшое количество мелких, тонкостенных сосудов. Очаги некроза и кисты для медуллобластом не типичны. Рост новообразования инфильтративный с прорастанием прилежащей ткани и мягкой оболочки мозга[4].
Метастазируют медуллобластомы главным образом по путям оттока спинномозговой жидкости в мягкую оболочку головного и спинного мозга и эпендиму желудочов мозга. В области метастазирования макроскопически определяют плоские, сливающиеся между собой белесоватые узелки, которые переходят в диффузные разрастания. Крайне редко медуллобластомы метастазируют за пределы центральной нервной системы[4].
Классификация
В 1969 году была предложена классификация медуллобластом, основанная на принципах TNM[17]. Впоследствии она была несколько модифицирована[1].
| Обозначение | Характеристика |
|---|---|
| Опухоль менее 3 см в диаметре, располагается в пределах червя мозжечка и крыши IV желудочка | |
| Опухоль более 3 см в диаметре, прорастает в соседние структуры или частично заполняет IV желудочек головного мозга | |
| Опухоль более 3 см в диаметре с прорастанием либо в область водопровода мозга, либо в отверстия Люшка и Мажанди, что вызывает развитие гидроцефалии | |
| Опухоль более 3 см в диаметре с прорастанием в ствол мозга | |
| Опухоль более 3 см в диаметре, которая вызывает гидроцефалию за счёт перекрытия путей оттока ликвора (либо водопровода мозга, либо отверстий Люшка и Мажанди) и прорастает в ствол мозга | |
| Нет метастазирования | |
| В ликворе при проведении микроскопических исследований определяются опухолевые клетки | |
| Метастазы в пределах субарахноидального пространства III и IV желудочков головного мозга | |
| Метастазы в субарахноидальном пространстве спинного мозга | |
| Метастазы за пределы центральной нервной системы |
Классификация имеет непосредственное прикладное значение. В зависимости от типа медуллобластомы определяют прогноз каждому конкретному больному.
Клиническая картина
Клинические симптомы заболевания включают проявления гидроцефалии и повышения внутричерепного давления, а также непосредственного поражения срединных отделов мозжечка. Клинически синдром внутричерепной гипертензии и гидроцефалия проявляются головной болью, нередко вынужденным положением головы, тошнотой, рвотой. Возможны расстройства сознания, судорожные припадки[1].
Поражение мозжечка, прежде всего его червя (архи- и палеоцеребеллума), вызывает нарушение статики тела — способности поддержания стабильного положения его центра тяжести, обеспечивающего устойчивость. При расстройстве указанной функции возникает статическая атаксия (греч. ἀταξία — беспорядок). Больной становится неустойчивым, поэтому в положении стоя он стремится широко расставить ноги, балансирует руками. Особенно чётко статическая атаксия проявляется в позе Ромберга. Больному предлагают встать, плотно сдвинув ступни, слегка поднять голову и вытянуть вперёд руки. При наличии мозжечковых расстройств человек в этой позе оказывается неустойчивым, тело его раскачивается. Больной может упасть[18][19].
Походка у пациента с мозжечковой патологией весьма характерна и носит название «мозжечковой». Больной в связи с неустойчивостью тела идёт неуверенно, широко расставляя ноги, при этом его «бросает» из стороны в сторону, а при поражении полушария мозжечка отклоняется при ходьбе от заданного направления в сторону патологического очага. Особенно отчётлива неустойчивость при поворотах. Во время ходьбы туловище человека избыточно выпрямлено (симптом Тома). Походка при поражении мозжечка во многом напоминает походку пьяного человека[18].
Диагностика
В типичных случаях на КТ медуллобластомы определяются как объёмные образования круглой или овальной формы, которые неоднородно накапливают контрастное вещество и располагаются в проекции червя мозжечка. Данные новообразования смещают IV желудочек вентрально. Достаточно часто определяются кисты (до 65 %) и микрокальцинаты[20].
На МРТ характеризуется гетерогенно изменённым сигналом, пониженным на Т1-взвешенных изображениях. На Т2-взвешенных томограммах сигнал варьирует от гипо- до гиперинтенсивного. На снимках в сагиттальной проекции хорошо определяется расположение как верхнего, так и нижнего полюса опухоли, который обычно располагается в большой затылочной цистерне[20].
При наличии у пациента медуллобластомы рекомендовано проведение МР-исследования спинного мозга, что позволяет судить о наличии или отсутствии метастазов[20].
При проведении обследования с введением контрастных веществ происходит их неоднородное накопление в различных отделах опухоли. Метастазирование медуллобластомы по мягким мозговым оболочкам спинного и головного мозга лучше определяется после введения контрастных веществ[20].
Лечение
Лечение данной патологии должно быть комплексным. Терапия представляет собой комбинацию хирургического лечения и химиотерапия. У некоторых пациентов используется лучевая терапия[5][6].
Для доступа к срединно расположенным медуллобластомам мозжечка необходимо вскрыть заднюю черепную ямку. В большинстве случаев во время операции также удаляют задние полудуги 1-го и 2-го шейных позвонков. Внедрение опухоли в ствол мозга или её прикрепление к дну IV желудочка ограничивает и делает невозможным её полное удаление[6].
В 30—40 % случаев после удаления медуллобластомы необходимо проведение вентрикуло-перитонеального шунтирования. Риск метастазирования по шунту оценивается в 10—20 %[5][6].
После удаления основного очага производится лучевая терапия. Оптимальными дозами являются 35—40 Гр на весь краниоспинальный отдел и 10—15 Гр на любой участок спинного мозга, где имеются метастазы. Лучевая терапия проводится в течение 6—7 недель. Детям до 3 лет дозу облучения снижают на 20—25 %[6][21]. В свою очередь лучевая терапия может вызывать целый ряд осложнений в виде поражения кожи, слизистых оболочек желудочно-кишечного тракта, угнетение кроветворения[22].
Для лечения рецидивов, а также у пациентов с высоким риском рецидивирования и детей до 3 лет в основном используют ломустин и винкристин[6]. Применяемые при химиотерапии лекарственные средства действуют токсически не только на ткань опухоли, но и на здоровые органы и ткани организма. В результате могут возникать токсические поражения кроветворения, желудочно-кишечного тракта, печени, сердца, мочевыводящей системы. Возможно возникновение аллергических реакций[23].
Прогноз
Выделяют две прогностические группы — низкого и высокого риска. К группе низкого риска относятся больные с опухолями Т1 или Т2, при отсутствии метастазирования М0 (согласно модифицированной классификации Чанга), дети старше 3-х лет, тотальное удаление опухоли. Медуллобластомы Т3—Т4 (согласно классификации Чанга), метастазирование (М1—М4), возраст менее 3-х лет, а также субтотальное удаление опухоли — группа высокого риска[24]. Пятилетняя выживаемость (количество больных, которые живы через 5 лет после операции) в группе низкого риска составляет около 75 %, в группе высокого — менее 35 %[5][6].
Наихудший прогноз заболевания у больных с рецидивом опухоли после операции. Средняя продолжительность жизни после выявления роста опухоли на исходном месте после её удаления составляет 13—18 месяцев[7][25].
Примечания
- ↑ 1 2 3 4 5 6 Kunshner L. J., Lang F. F. Medulloblastoma // Youmans Neurological Surgery / ed. by H. R. Winn. — 5th edition. — Philadelphia, PA: SAUNDERS, 2004. — Vol. 1. — P. 1031—1042. — ISBN 0-7216-8291-X.
- ↑ 1 2 Hart M. N., Earle K. M. Primitive neuroectodermal tumors of the brain in children (англ.) // Cancer (журнал). — Wiley-Blackwell, 1973. — Vol. 32. — P. 890—897. — PMID 4751919.
- ↑ 1 2 Davis F. G., Freels S., Grutsch J., Barlas S., Brem S. Survival rates in patients with primary malignant brain tumors stratified by patient age and tumor histological type: an analysis based on Surveillance, Epidemiology, and End Results (SEER) data, 1973-1991 // J Neurosurg. — 1998. — Vol. 88. — P. 1—10. — PMID 9420066.
- ↑ 1 2 3 4 5 Бродская И. А. Медуллобластома // Большая медицинская энциклопедия / под общей редакцией Б. В. Петровского. — 3-е издание. — М.: «Советская энциклопедия», 1980. — Т. 14. — С. 458—459. — 496 с. — 150 000 экз.
- ↑ 1 2 3 4 5 Медуллобластома. Первый московский государственный медицинский университет имени И. М. Сеченова. Дата обращения: 18 ноября 2011. Архивировано из оригинала 31 января 2012 года.
- ↑ 1 2 3 4 5 6 7 8 Гринберг М. С. Медуллобластома // Нейрохирургия. — М.: Медпресс-информ, 2010. — С. 491. — 1008 с. — 1000 экз. — ISBN 978-5-98322-550-3.
- ↑ 1 2 Torres C. F., Rebsamen S., Silber J. H., Sutton L. N., Bilaniuk L. T., Zimmerman R. A., Goldwein J. W., Phillips P. C., Lange B. J. Surveillance scanning of children with medulloblastoma // N Engl J Med. — 1994. — Vol. 330. — P. 892—895. — PMID 8114859.
- ↑ Bailey P., Cushing H. Medulloblastoma cerebelli: A common type of midcerebellar glioma of childhood // Arch Neurol Psychiatry. — 1925. — Vol. 14. — P. 192—224.
- ↑ Rorke L. B. The cerebellar medulloblastoma and its relationship to primitive neuroectodermal tumors // J Neuropathol Exp Neurol. — 1983. — Vol. 42. — P. 1—15. — PMID 6296325.
- ↑ Becker L. E., Hinton D. Primitive neuroectodermal tumors of the central nervous system // Hum Pathol. — 1983. — Vol. 14. — P. 538—550. — PMID 6303940.
- ↑ Kleihues P., Burger P. C., Scheithauer B. W. The new WHO classification of brain tumours // Brain Pathol.. — 1993. — Vol. 3. — P. 255—268. — PMID 8293185.
- ↑ Polednak A. P., Flannery J. T. Brain, other central nervous system, and eye cancer (англ.) // Cancer (журнал). — Wiley-Blackwell, 1995. — Vol. 75 (Suppl 1). — P. 330—337. — PMID 8001004.
- ↑ Bloom H. J., Bessell E. M. Medulloblastoma in adults: a review of 47 patients treated between 1952 and 1981 // Int J Radiat Oncol Biol Phys. — 1990. — Vol. 18. — P. 763—772. — PMID 2323967.
- ↑ Giordana M. T., Schiffer P., Lanotte M., Girardi P., Chio A. Epidemiology of adult medulloblastoma // Int J Cancer. — 1999. — Vol. 80. — P. 689—692. — PMID 10048968.
- ↑ Farwell J. R., Flannery J. T. Adult occurrence of medulloblastoma // Acta Neurochir (Wien). — 1987. — Vol. 86. — P. 1—5. — PMID 3618300.
- ↑ Agerlin N., Gjerris F., Brincker H., Haase J., Laursen H., Møller K. A., Ovesen N., Reske-Nielsen E., Schmidt K. Childhood medulloblastoma in Denmark 1960-1984. A population-based retrospective study // Childs Nerv Syst. — 1999. — Vol. 15. — P. 29—36. — PMID 10066017.
- ↑ Chang C. H., Housepian E. M., Herbert C. Jr. An operative staging system and a megavoltage radiotherapeutic technic for cerebellar medulloblastomas // Radiology. — 1969. — Vol. 93. — P. 1351—1359. — PMID 4983156.
- ↑ 1 2 Пулатов А. М, Никифоров А. С. Пропедевтика нервных болезней. — Т.:: «Медицина», 1979. — С. 108—120. — 368 с. — 20 000 экз.
- ↑ Триумфов А. В. Топическая диагностика заболеваний нервной системы. — 9-е изд.. — М.: ООО «МЕДпресс», 1998. — С. 177—185. — 304 с. — 5000 экз. — ISBN 5-900990-04-4.
- ↑ 1 2 3 4 Коновалов А. Н., Корниенко В. Н., Пронин И. Н. Медуллобластомы // Магнитно-резонансная томография в нейрохирургии. — М.: «ВИДАР», 1997. — С. 259—260. — 472 с. — 1500 экз. — ISBN 5-88429-022-5.
- ↑ Tomita T., McLone D. G. Medulloblastoma in childhood: results of radical resection and low-dose neuraxis radiation therapy // J Neurosurg. — 1986. — Vol. 64. — P. 238—242. — PMID 3944633.
- ↑ Лучевая терапия: осложнения, общие сведения. сайт medbiol.ru. Дата обращения: 23 ноября 2011. Архивировано 9 декабря 2011 года.
- ↑ Побочные реакции и осложнения химиотерапии опухолевых заболеваний (недоступная ссылка — история). сайт Противоракового общества России. Дата обращения: 23 ноября 2011. Архивировано 31 января 2012 года.
- ↑ Packer R. J., Cogen P., Vezina G., Rorke L. B. Medulloblastoma: clinical and biologic aspects // Neuro Oncol. — 1999. — Vol. 1. — P. 232—250. — PMID 11550316.
- ↑ Dunkel I. J., Gardner S. L., Garvin J. H. Jr, Goldman S., Shi W., Finlay J. L. High-dose carboplatin, thiotepa, and etoposide with autologous stem cell rescue for patients with previously irradiated recurrent medulloblastoma // Neuro Oncol. — 2010. — Vol. 12. — P. 297—303. — PMID 20167818.